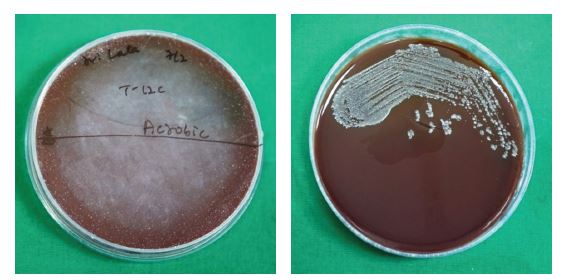
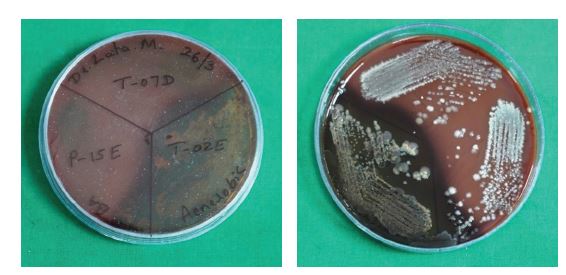
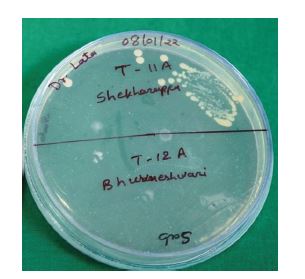

RGUHS Nat. J. Pub. Heal. Sci Vol No: 17 Issue No: 4 pISSN:
Dear Authors,
We invite you to watch this comprehensive video guide on the process of submitting your article online. This video will provide you with step-by-step instructions to ensure a smooth and successful submission.
Thank you for your attention and cooperation.
1Dr. Lata S Mushannavar, Department of Prosthodontics, SDM College of Dental Sciences and Hospital, Shri Dharmasthala Manjunatheshwara University, Dharwad, Karnataka, India.
2Department of Prosthodontics, SDM College of Dental Sciences and Hospital, Shri Dharmasthala Manjunatheshwara University, Dharwad, Karnataka, India
3Department of Conservative Dentistry, Government Dental College and Research Institute, Bengaluru, Karnataka, India
4Consultant Microbiologist, Arihant Super Specialty Hospital, Nehru Nagar, Belagavi, Karnataka, India
5Department of Public Health Dentistry, SDM College of Dental Sciences and Hospital, Shri Dharmasthala Manjunatheshwara University, Dharwad, Karnataka, India
*Corresponding Author:
Dr. Lata S Mushannavar, Department of Prosthodontics, SDM College of Dental Sciences and Hospital, Shri Dharmasthala Manjunatheshwara University, Dharwad, Karnataka, India., Email: drlata7@gmail.com
Abstract
Background: Current treatment protocols for patients diagnosed with denture stomatitis are under scrutiny, and alternative options are being explored by researchers. Silver nano modified denture base resins can significantly reduce the presence of infection at the point of contact between the denture and the mucous membrane of the prosthetic restoration.
Aim: The aim of the present study was to develop silver nano modified antimicrobial PMMA denture base resin for complete denture fabrication.
Methods: In the present study the biosynthesised silver nanoparticles were incorporated into Poly Methyl Methacrylate (PMMA) there by forming nano modified PMMA denture base resin. Further, its antimicrobial activity against microbes associated with denture stomatitis in complete denture wearers was assessed by determining the reduction in colony forming units.
Results: Silver nano modified complete dentures exhibited significant (P<0.05) reduction in the number of colony forming units as compared to unmodified PMMA complete denture wearers.
Conclusion: Within the limitations of the study, it was concluded that the silver nanomodified complete denture wearers demonstrated long term antimicrobial activity as compared to the complete denture wearers without modification. Thus, the biosynthesized silver nanomodified PMMA would be a promising denture base material for complete denture fabrication in the prevention and management of denture stomatitis. There by improving the overall health and quality of life.
Keywords
Downloads
-
1FullTextPDF
Article
Introduction
Traditional acrylic dentures remain the most common tooth replacement method, although the use of dental implants is increasing. Polymethyl methacrylate (PMMA), due to its favourable material properties, is the most commonly used material for the fabrication of denture base.1
The porous surface of PMMA resins can promote plaque accumulation, thereby altering the oral flora and leading to oral infections.2 A significant concern with biofilm formation on acrylic denture surfaces is its association with various oral health issues, including denture stomatitis, erythema, chronic mucositis, periodontitis, and dental caries. Additionally, it may be linked to systemic conditions such as pneumonia and gastrointestinal disorders.1
Denture stomatitis (DS) is a form of oral candidiasis characterized by inflammation of the mucosal tissue beneath a full or partial removable denture. Studies indicate that 11-67% of individuals who wear complete dentures experience denture stomatitis, with a higher prevalence among women.3,4 There is a hydrophobic interaction between Candida albicans and denture materials, which facilitate surface biofilm attachment.4 The use of antimicrobial mouthwashes, tooth brushing, and prophylactic systemic antibiotics has shown limited success. Moreover, the use of antibiotics in patients with poor compliance may potentially promote the development of antibiotic-resistant bacterial strains.5 Frequent recurrence of infections and the absence of a universally accepted treatment protocol make management of DS particularly challenging.3
Nanotechnology offers potential solutions to this problem. Silver nanoparticles (AgNPs) have been extensively investigated for their strong antibacterial properties, low toxicity to humans, cost-effectiveness, and reduced potential for antimicrobial resistance.6 Incorporation of silver nanoparticles into the acrylic resin used for denture fabrication could be a promising strategy.
Thus, the aim of the present study was to evaluate the antimicrobial activity of silver nanoparticle-modified PMMA denture base resin. The null hypothesis stated that the incorporation of silver nanoparticles into heatcured PMMA resin does not enhance its antimicrobial effect compared with conventional acrylic resin in complete denture wearers.
Materials and Methods
Study Design and Setting
This single-blind, controlled clinical trial was conducted among edentulous patients requiring complete dentures who reported to the Department of Prosthodontics. The study commenced after receiving approval from the Institutional Ethics Committee (2018/P/PROS/87). It was conducted in compliance with the principles enunciated in the Helsinki Declaration (1975), as revised in 2000.7
Sample Size Estimation
G* Power version 3.1.9.7 was used for sample size estimation. Considering a study power of 80% and a significance level of 5%, the sample size was calculated using hypothesis testing for two means, which yielded 25 participants per group (n=25 per group). Considering possible dropouts, the sample size was increased by 10%, resulting in a total sample size of 28 participants per group. This number was further rounded to 30 participants per group.
Inclusion Criteria
The study included completely edentulous patients requiring new dentures. Only non-smoker patients with healthy oral tissues aged above 55 years were included. Specific arch forms and relationships were not considered as inclusion factors.
Exclusion Criteria
Individuals wearing partial dentures, patients presently on antifungal or antibacterial therapy, or those who had taken antibiotics within the past six months were excluded. Additionally, patients with HIV or other immune compromised conditions, individuals allergic to metal, and those not willing to participate were excluded.
Synthesis of Silver Nanoparticles
Silver nanoparticles (AgNPs) were synthesized using a leaf extract obtained from Trigonella foenum graecum, as described in our previous study (Figure 1).8 The sythesized AgNPs were spherical in shape, with particle sizes ranging between 70 to 90 nm, and their anti-microbial activity against key microorganisms associated with denture stomatitis was established in the previous research.8
Procedure
The study protocol and objectives were explained to all participants in simple, understandable language, and any concerns were addressed. Informed consent was then obtained from each participant.
Participants were allocated into two groups as follows:
Group A (n=30): Control group (complete dentures without AgNPs)
Group B (n=30): Test group (complete dentures with silver nanoparticle-modified PMMA)
Complete dentures were fabricated using PMMA denture base material following the standard denture fabrication protocol for both groups. After the clinical trial of the waxed-up dentures, the control group dentures were processed without any modification. For the test group, silver nanoparticles at a concentration of 32 μg/ mL were incorporated into the monomer of heat-cured PMMA resin and stirred using a magnetic stirrer for 10 minutes to reduce agglomeration and ensure uniform dispersion of AgNPs. The resultant monomer was then mixed with the PMMA polymer in a 3:1 volume ratio. Dentures were fabricated by flasking and compression-moulding according to the standard denture fabrication protocol, followed by polishing.9 The dentures were stored in distilled water for 24 hours to allow leaching of any residual monomer. Finally, the dentures were inserted, and participants were provided with post insertion instructions.
Assessment of Antimicrobial Activity
The antimicrobial effect of complete dentures in both groups was evaluated by counting the number of cultivable cells in the biofilm, determined through enumeration of colony forming units (CFUs). Briefly, after the specified time interval, participants were recalled for sample collection. Swabs were collected in the morning, and participants were asked to wear their prosthesis continuously and refrain from rinsing for at least four hours prior to sample collection. Swabs were obtained from the entire tissue-contacting surface of each complete denture at the following intervals: day 1 (T1), 1 week (T2), 1 month (T3), 3 months (T4), and 6 months (T5). Swabs collected from both the test and control groups were stored in reduced transport fluid (RTF) and transported to the microbiology laboratory for assessment of antimicrobial activity (Figure 2).
Samples received in RTF were vortexed at 4000 rpm for 10-15 minutes, diluted at a 1:10 ratio, and subsequently inoculated onto blood agar (BA) medium. Blood agar, specifically Brucella agar supplemented with hemin and vitamin K, served as an enriched medium. One plate was incubated aerobically, and the other anaerobically in an anaerobic jar for 48 to 72 hours at 37 0C.
For Candida species, samples were incubated on Sabouraud’s dextrose agar (SDA), a selective medium for fungal growth. After incubation, microbial growth was examined, and colonies were counted using a colony counter to determine CFU/mL for quantification.10
Statistical Analysis
All measurements were taken in triplicate. Mean and standard deviation were calculated for descriptive analysis. Data were statistically analyzed using SPSS version 20 (IBM, SPSS software Inc.) with the independent samples t-test. A P <0.05 was considered statistically significant.
Results
A total of 64 participants were initially recruited for the study. Following the withdrawal of four participants, 60 participants successfully completed the study. The antibacterial activity of AgNPs against aerobic bacteria, anaerobic bacteria, and Candida albicans was evaluated by determining the number of colony-forming units (CFUs). A statistically significant antimicrobial effect was observed from T2 (at one-week interval) onwards. Representative CFU images of aerobic bacteria, anaerobic bacteria, and C. albicans (CA) are shown in Figure 3(a-c), respectively.
The mean and standard deviation of CFU counts for the control group (Group A) and the test group (Group B) at various time intervals at day 1 (T1), 1 week (T2), 1 month (T3), 3 months (T4), and 6 months (T5), are presented in Table 1. When compared using the independent samples t-test across time intervals from T2 to T5, Group A showed significantly higher CFU values compared to Group B for aerobic bacteria, anaerobic bacteria, and C. albicans. This finding indicates that Group B demonstrated greater antimicrobial activity from T2 to T5. However, at T1, no significant difference was observed between the two groups for any of the tested microorganisms (Table 1). The mean CFU values across all time points (T1 to T5) for aerobes, anaerobes, and C. albicans (CA) are illustrated in Figure 4.
Discussion
One potential approach for preventing or reducing microbial adhesion on the fitting surface of prostheses is the modification of denture base resins through the incorporation of antimicrobial agents. The use of antibiotics and antifungals is limited by several factors, including contraindications, side effects, and the short duration of their treatment. Silver has long been acknowledged for its broad-spectrum antimicrobial properties. Silver nanoparticles (AgNPs) exhibit potent antimicrobial activity, good biocompatibility, and have been used in various biomedical applications to eliminate pathogenic microorganisms. The addition of nanoparticles (NPs) into denture base resins aims to inhibit and minimize the colonization of microorganisms, thereby promoting oral health. AgNPs can be integrated with polymers, smears, or liners on biomaterial surfaces, potentially treating and preventing oral infections.11,12
The aim of this study was to assess the antimicrobial activity of silver nanoparticle modified PMMA denture base resin. In this study, AgNPs were incorporated into the monomer of PMMA resin, and their antimicrobial efficacy was evaluated. This easily accessible and cost-effective approach may represent a promising method for imparting antimicrobial properties to dentures, offering particular benefits for the elderly population. A review of the existing literature revealed no prior studies demonstrating long-term antimicrobial activity lasting up to six months.
The null hypothesis stated that AgNP incorporation into heat-cured PMMA resin does not exhibit any antimicrobial effect in complete denture wearers. However, the addition of AgNPs to acrylic resin was found to inhibit microbial growth, with the extent of inhibition being directly related to the concentration of nanoparticles.
Biocompatibility is a crucial factor in determining the safety of any material for human use. Although AgNPs exhibit antibacterial properties and have demonstrated diverse biological applications, their use as a therapeutic agent is restricted due to potential cytotoxic effects on mammalian cells.13 In our previous study, we investigated the cytotoxic effects of AgNPs on normal mammalian fibroblast cells and observed that increasing AgNP concentration led to a dose-dependent decrease in cell survival rate.8 In the present research work, AgNPs were incorporated into PMMA resin at a concentration below the cytotoxic threshold for healthy cell viability, thereby indicating their biocompatibility and suitability for use in denture base resin.
In the present in vivo study, samples were collected from the palatal mucosa of complete denture wearers, as denture stomatitis is most commonly observed at this site.4 The antimicrobial activity was assessed by quantitatively measuring CFU counts at day 1 (T1), which served as the baseline for subsequent comparisons at 1 week (T2), 1 month (T3), 3 months (T4), and 6 months (T5). The modified denture base, being in direct contact with the mucosa, allows the antimicrobial effect to remain effective even at lower concentrations. Therefore, AgNPs were incorporated at a concentration of 32 μg/mL, which had previously demonstrated significant antimicrobial activity.8 The mechanism of action of plant-mediated AgNPs is reported to be due to the attachment to the microbial cell surface, disruption of cell membrane, and interaction with intracellular organelles.14 Swab samples were collected in the morning, and participants were instructed not to rinse for a minimum of four hours prior to sampling to ensure adequate salivary accumulation and microbial load.
In the current study, antimicrobial activity was observed beginning at the T2 time interval, in contrast to our in vitro findings, which demonstrated significant antimicrobial activity from the T1 time interval onward. The probable reason for this difference may be the influence of salivary flow and the release of nanosilver into the oral cavity. The composition of the microflora varies across different sites in the oral cavity, which may be attributed to “site-specific physical and biological characteristics like receptors for microbial adhesion, redox potential, availability of essential nutrients and the age of the host”.15
Conclusion
Silver nanoparticles were synthesized using Trigonella foenumgraecum leaves through a green method. A reduction in mean colony forming units in the test group was identified as the key finding in this study. Collectively, these results suggest that silver nanoparticle-modified PMMA can serve as an effective antimicrobial denture base resin. The biogenic AgNPs demonstrated strong antimicrobial activity, suggesting their potential application in denture fabrication. This alternative approach may offer a promising strategy for the management of denture stomatitis.
Conflict of Interest
No conflict of interest
Supporting File
References
1. Gligorijević N, Mihajlov-Krstev T, Kostić M, et al. Antimicrobial properties of silver-modified denture base resins. Nanomaterials 2022;12(14):2453.
2. Pourhajibagher M, Bahador A. Effects of incorporation of nanoparticles into dental acrylic resins on antimicrobial and physico-mechanical properties: A meta-analysis of in vitro studies. J Oral Biol Cranio-facial Res 2022;12(5):557-568.
3. Adam RZ, Khan SB. Antimicrobial efficacy of silver nanoparticles against Candida albicans. Materials 2022;15(16):5666.
4. Bajunaid SO. How effective are antimicrobial agents on preventing the adhesion of Candida albicans to denture base acrylic resin materials? A systematic review. Polymers 2022;14(5):908.
5. Fan C, Chu L, Rawls HR, et al. Development of an antimicrobial resin-A pilot study. Dent Mater 2011;27(4):322-328.
6. Jandt KD, Watts DC. Nanotechnology in dentistry: Present and future perspectives on dental nanomaterials. Dent Mater 2020;36(11):1365-1378.
7. Carlson RV, Boyd KM, Webb DJ. The revision of the Declaration of Helsinki: past, present and future. Br J Clin Pharmacol 2004;57(6):695-713.
8. Mushannavar LS, Nadiger RK, Kariduraganavar MY, et al. Development of silver nanoparticles using trigonella foenum graecum leaf extract and evaluation of their antimicrobial and noncytotoxic efficacy for dental applications. Int J Nanoparticles 2023;15(1):68-85.
9. da Silva Barboza A, Fang LK, Ribeiro JS, et al. Physicomechanical, optical, and antifungal properties of polymethyl methacrylate modified with metal methacrylate monomers. J Prosthet Dent 2021;125(4):706.e1-.e6.
10. Dm C. Bacteroides, Porphyromonas, Prevotella, Fusobacterium, and other anaerobic Gram-negative rods. Man Clin Microbiol 2007:911-932.
11. Song W, Ge S. Application of antimicrobial nanoparticles in dentistry. Molecules 2019;24(6):1033.
12. Kaur P, Luthra R. Silver nanoparticles in dentistry: An emerging trend. SRM J Res Dent Sci 2016;7(3):162.
13. Gopinath V, Priyadarshini S, Loke MF, et al. Biogenic synthesis, characterization of antibacterial silver nanoparticles and its cell cytotoxicity. Arab J Chem 2017;10(8):1107-1117.
14. Ghoshal G, Singh M. Characterization of silver nano-particles synthesized using fenugreek leave extract and its antibacterial activity. Mater Sci Energy Technol 2022;5:22-29.
15. Percival RS, Challacombe SJ, Marsh PD. Age-related microbiological changes in the salivary and plaque microflora of healthy adults. J Med Microbiol 1991;35(1):5-11.